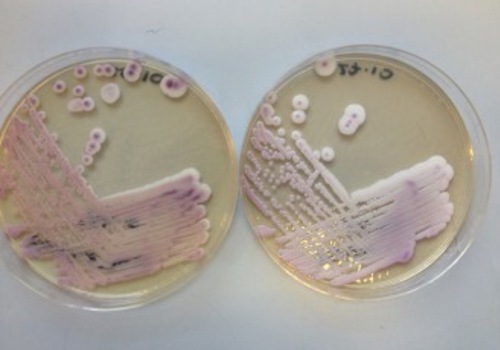

NCPF in Research: Update on the emerging pathogen Candida auris in the UK
A previous newsletter discussed a novel fungal pathogen, Candida auris. After its first description in 2009, C. auris had rapidly emerged as an important cause of nosocomial infections across several continents, with large outbreaks in hospitals in South Africa, India, parts of North and South America, Spain and the UK. Almost all isolates reported to date are resistant to the first line antifungal fluconazole, with some isolates showing resistance to several different classes of antifungal drugs and evidence of resistance to particular drugs emerging rapidly during antifungal therapy. Previous work conducted by the UK National Mycology Reference Laboratory (MRL) had shown that Candida auris was unexpectedly pathogenic when compared with other Candida species with similar growth characteristics1.
Sequencing (including whole genome sequencing) of isolates from various outbreaks has indicated that different continents have independent clonal lineages of the organism, with separate lineages specific to South America, the Indian subcontinent, South Africa and South-East Asia. Importantly, there appears to be very little genetic variation between isolates from a given lineage, but great variation between the lineages, indicating that this novel pathogen has recently independently emerged, simultaneously on three different continents2, although it is currently causing outbreaks in five continents.
In the UK, Candia auris has caused large outbreaks in at least three tertiary care centres, with sporadic cases in over 20 NHS trusts, and over 200 cases of infection or colonisation in total. In a recent collaborative study performed by the MRL, selected isolates from different UK centres were subjected to conventional and whole genome sequencing in an attempt to understand the UK epidemiology of this novel pathogen. The results clearly demonstrated that the UK does not possess “its own lineage” of C. auris, but has instead seen the introduction and circulation of strains indistinguishable from the clonal lineages found in S. Africa, the Indian subcontinent and SE Asia3. Moreover, strains belonging to more than one lineage were detected over short time spans in the same hospital. Taken together the data demonstrated conclusively that the large outbreaks of C. auris seen across the UK were a result of the combination of multiple novel introductions of the pathogen into healthcare settings, followed by widespread patient-patient transmission3.
Phylogenetic tree (based on rDNA sequences) of isolates of C. auris from the UK (asterisks) and isolates form the clonal lineages detected in S Africa, SE Asia (Japan/Korea) and the Indian subcontinent. UK strain designations are as follows: strain number, isolation hospital (uppercase letter), year of isolation, NCPF number.
NCPF has a wide selection of strains of many different Candida species, including examples of the S. African, Indian and SE Asian clades of Candida auris. Recently, some of these C. auris strains were employed to examine the activity of different chemical disinfectants and antiseptics against this important pathogen4, and to test the ability of the organism to form persistent biofilms5.
Related Links
References
- Borman AM, Sezekely A, Johnson EM. (2016). Comparative pathogenicity of UK isolates of the emerging pathogen Candida auris and other key pathogenic Candida species. mSphere (1)4. doi: 10.1128/mSphere.00189-16
- Lockhart SR, Etienne KA, Vallabhaneni S et al. 2016. Simultaneous emergence of multidrug resistant Candida auris on three continents confirmed by whole genome sequencing and epidemiological analyses. Clin Infect Dis. doi:10.1093/cid/ciw691.
- Borman AM, Szekely A, Johnson EM. (2017). Isolates of the emerging pathogen Candida auris present in the UK have several geographic origins.Med Mycol. 55(5):563-567. doi: 10.1093/mmy/myw147.
- Moore G, Schelenz S, Borman AM, Johnson EM, Brown CS. (2017). Yeasticidal activity of chemical disinfectants and antiseptics against Candida auris.J Hosp Infect. 97(4):371-375. doi: 10.1016/j.jhin.2017.08.019
- Sherry L, Ramage G, Kean R, Borman A, Johnson EM, Richardson MD, Rautemaa-Richardson R. (2017). Biofilm-forming capability of highly virulent, multidrug-resistant Candida auris. Emerg Infect Dis. 23(2):328-331. doi: 10.3201/eid2302.161320